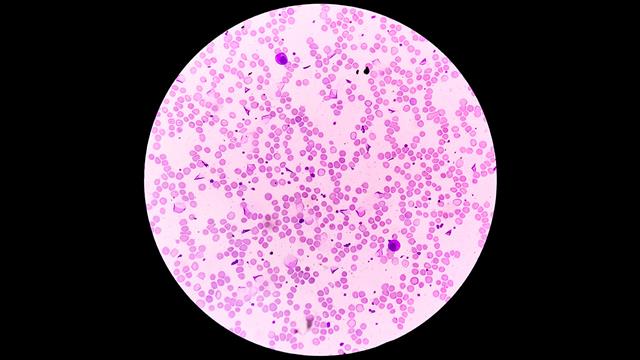
Η Agios έλαβε τη θετική γνωμοδότηση για το Pyrukynd

Η Avanzanite Bioscience B.V. σήμερα ανακοίνωσε ότι η συνεργάτης της εταιρεία Agios Pharmaceuticals, Inc., γνωστοποίησε ότι η Επιτροπή Φαρμακευτικών Προϊόντων για Ανθρώπινη Χρήση (CHMP) του Ευρωπαϊκού Οργανισμού Φαρμάκων (EMA) υιοθέτησε θετική γνωμοδότηση για τη νέα ένδειξη του Pyrukynd® (mitapivat).
Αφορά μιας από του στόματος θεραπείας, του ενεργοποιητή της πυροσταφυλικής κινάσης (PK), για τη θεραπεία της αναιμίας που σχετίζεται με εξαρτώμενη ή μη εξαρτώμενη από μεταγγίσεις άλφα - ή βήτα - θαλασσαιμία σε ενήλικες.
Τον Ιούνιο του 2025, η Avanzanite υπέγραψε αποκλειστική συμφωνία με την Agios για την εμπορική διάθεση και διανομή του PYRUKYND σε ολόκληρο τον Ευρωπαϊκό Οικονομικό Χώρο, το Ηνωμένο Βασίλειο και την Ελβετία.
"Η θετική γνωμοδότηση της CHMP για το Pyrukynd αποτελεί ένα κρίσιμο βήμα προς τη διάθεση αυτής της θεραπείας σε ενήλικες ασθενείς με θαλασσαιμία - μια κοινότητα με επείγουσα θεραπευτική ανάγκη", δήλωσε ο δρ Mark Bechter, ανώτερος αντιπρόεδρος Ιατρικών Υποθέσεων της Avanzanite. "Αναμένουμε να συνεργαστούμε στενά με την Agios, ώστε να διασφαλίσουμε την πρόσβαση των ασθενών σε αυτή τη θεραπεία σε όλη την Ευρώπη, εν αναμονή της έγκρισης από την Ευρωπαϊκή Επιτροπή", πρόσθεσε.
Η θετική γνωμοδότηση της CHMP βασίζεται στα αποτελέσματα των παγκόσμιων, τυχαιοποιημένων, διπλά τυφλών, ελεγχόμενων με εικονικό φάρμακο μελετών ENERGIZE-T και ENERGIZE Φάσης 3, σε ενήλικες με μεταγγισιοεξαρτώμενη και μη μεταγγισιοεξαρτώμενη άλφα - ή βήτα - θαλασσαιμία, αντίστοιχα. Η Ευρωπαϊκή Επιτροπή θα εξετάσει τώρα τη γνωμοδότηση της CHMP και, σύμφωνα με την Agios, η τελική απόφαση αναμένεται στις αρχές του 2026.
Σχετικά με τη Θαλασσαιμία
Η θαλασσαιμία είναι μια σπάνια, κληρονομική αιματολογική νόσος που επηρεάζει την παραγωγή της αιμοσφαιρίνης, της πρωτεΐνης των ερυθρών αιμοσφαιρίων που είναι υπεύθυνη για τη μεταφορά οξυγόνου σε όλο το σώμα.
Η νόσος διακρίνεται σε δύο κύριους τύπους - άλφα - θαλασσαιμία και βήτα - θαλασσαιμία - ανάλογα με το ποια αλυσίδα της σφαιρίνης της αιμοσφαιρίνης επηρεάζεται. Με τη διαταραχή της παραγωγής αιμοσφαιρίνης, η θαλασσαιμία μειώνει τον αριθμό των κυκλοφορούντων ερυθρών αιμοσφαιρίων και συντομεύει τη διάρκεια γεγονός που οδηγεί σε αναιμία, κόπωση και σοβαρές επιπλοκές.
Υπάρχουν ασθενείς με θαλασσαιμία που χρειάζονται τακτικές μεταγγίσεις αίματος (κατηγοριοποιούνται ως ασθενείς με μεταγγισιοεξαρτώμενη θαλασσαιμία), ενώ άλλοι χρειάζονται μεταγγίσεις περιστασιακά (κατηγοριοποιούνται ως ασθενείς με μη μεταγγισιοεξαρτώμενη θαλασσαιμία). Ωστόσο, οι περισσότεροι ασθενείς με θαλασσαιμία αντιμετωπίζουν σημαντικό φορτίο νόσου, που περιλαμβάνει συννοσηρότητες, μειωμένη ποιότητα ζωής και μικρότερο προσδόκιμο επιβίωσης.
Σχετικά με τις μελέτες
Οι μελέτες ENERGIZE ( NCT04770753 ) και ENERGIZE-T ( NCT04770779 ) είναι παγκόσμιες, τυχαιοποιημένες, διπλά τυφλές, ελεγχόμενες με εικονικό φάρμακο κλινικές μελέτες Φάσης 3, που αξιολογούν την αποτελεσματικότητα και την ασφάλεια του mitapivat σε ενήλικες με άλφα- ή βήτα-θαλασσαιμία. Η μελέτη ENERGIZE τυχαιοποίησε 194 ασθενείς με μη μεταγγισιοεξαρτώμενη θαλασσαιμία σε αναλογία 2:1, ώστε να λάβουν είτε mitapivat 100 mg δύο φορές ημερησίως, είτε εικονικό φάρμακο (placebo).
Το πρωτεύον καταληκτικό σημείο ήταν το ποσοστό των ασθενών που πέτυχαν ανταπόκριση στην αιμοσφαιρίνη, οριζόμενο ως αύξηση ≥1,0 g/dL στη μέση συγκέντρωση αιμοσφαιρίνης από την εβδομάδα 12 έως την εβδομάδα 24, σε σύγκριση με τις αρχικές τιμές (baseline). Τα κύρια δευτερεύοντα καταληκτικά σημεία περιλάμβαναν τις μεταβολές από το baseline στις βαθμολογίες της Κλίμακας FACIT - Fatigue (Functional Assessment of Chronic Illness Therapy–Fatigue) και στη μέση συγκέντρωση αιμοσφαιρίνης από την εβδομάδα 12 έως την εβδομάδα 24. Η μελέτη αξιολόγησε επίσης την ασφάλεια και την ανεκτικότητα της θεραπείας.
Η μελέτη ENERGIZE-T τυχαιοποίησε 258 ασθενείς με μεταγγισιοεξαρτώμενη θαλασσαιμία σε αναλογία 2:1, ώστε να λάβουν είτε mitapivat 100 mg δύο φορές ημερησίως, είτε εικονικό φάρμακο (placebo). Το πρωτεύον καταληκτικό σημείο ήταν το ποσοστό των ασθενών που πέτυχαν ανταπόκριση στη μείωση των μεταγγίσεων (Transfusion Reduction Response - TRR), οριζόμενο ως μείωση ≥50% στον αριθμό των μεταγγισμένων μονάδων ερυθρών αιμοσφαιρίων (RBC), με ταυτόχρονη μείωση ≥2 μονάδων σε οποιαδήποτε συνεχή περίοδο 12 εβδομάδων έως και την εβδομάδα 48.
Περιλήφθηκαν επίσης πολλαπλά επιπρόσθετα μέτρα μείωσης των μεταγγίσεων ως κύρια δευτερεύοντα καταληκτικά σημεία, ενώ η επίτευξη ανεξαρτησίας από μεταγγίσεις αποτέλεσε δευτερεύον καταληκτικό σημείο. Η μελέτη αξιολόγησε επίσης την ασφάλεια και την ανεκτικότητα της θεραπείας.
Ειδήσεις υγείας σήμερα
Πώς μπορώ να προλάβω την αρθρίτιδα
Τρίτη διαδοχική πιστοποίηση BCorp για την Chiesi Hellas
Η GENESIS Pharma ανακοινώνει νέα συνεργασία με την Otsuka Pharmaceutical Europe Ltd
Συνάντηση με την ηγεσία του υπουργείου Υγείας
Συνάντηση με την ηγεσία του υπουργείου Υγείας Ελληνική Ομοσπονδία Θαλασσαιμίας: Επικίνδυνο το Position Paper του ΣΦΕΕ
Ελληνική Ομοσπονδία Θαλασσαιμίας: Επικίνδυνο το Position Paper του ΣΦΕΕ Συνάντηση εργασίας Προέδρου Ε.ΚΕ.Α.-Εκπροσώπων ασθενών με Θαλασσαιμία
Συνάντηση εργασίας Προέδρου Ε.ΚΕ.Α.-Εκπροσώπων ασθενών με Θαλασσαιμία Έκκληση για εθελοντική αιμοδοσία από την Ελληνική Ομοσπονδία Θαλασσαιμίας
Έκκληση για εθελοντική αιμοδοσία από την Ελληνική Ομοσπονδία Θαλασσαιμίας Χρήση του συστήματος αποθήκευσης υποξικών ερυθρών αιμοσφαιρίων Hemanext One® για μετάγγιση σε ασθενείς με θαλασσαιμία
Χρήση του συστήματος αποθήκευσης υποξικών ερυθρών αιμοσφαιρίων Hemanext One® για μετάγγιση σε ασθενείς με θαλασσαιμία Η Διεθνής Ομοσπονδία Θαλασσαιμίας κυκλοφορεί τη 2η έκδοση του οδηγού ''Γνώρισε τα Δικαιώματά σου''
Η Διεθνής Ομοσπονδία Θαλασσαιμίας κυκλοφορεί τη 2η έκδοση του οδηγού ''Γνώρισε τα Δικαιώματά σου'' Πώς μπορώ να προλάβω την αρθρίτιδα
Πώς μπορώ να προλάβω την αρθρίτιδα Healthcare Transformation - Λ. Βιλδιρίδη: Ενιαίος χάρτης για τα ιατροτεχνολογικά του ΕΣΥ [βίντεο]
Healthcare Transformation - Λ. Βιλδιρίδη: Ενιαίος χάρτης για τα ιατροτεχνολογικά του ΕΣΥ [βίντεο] Healthcare Transformation - Γεωργιάδης: Το clawback και η σύγκριση με τη Γερμανία [βίντεο]
Healthcare Transformation - Γεωργιάδης: Το clawback και η σύγκριση με τη Γερμανία [βίντεο] Οι προκλήσεις στο Φάρμακο: Οι πράξεις, η θεωρία και οι παγκόσμιες αλλαγές
Οι προκλήσεις στο Φάρμακο: Οι πράξεις, η θεωρία και οι παγκόσμιες αλλαγές Πώς επιδρούν στην ημικρανία τα ενέσιμα φάρμακα για το αδυνάτισμα
Πώς επιδρούν στην ημικρανία τα ενέσιμα φάρμακα για το αδυνάτισμα Β. Πενταφράγκας στο Healthcare Transformation: Χρήματα από το RRF για προσδιορισμό των πραγματικών αναγκών στην Υγεία [βίντεο]
Β. Πενταφράγκας στο Healthcare Transformation: Χρήματα από το RRF για προσδιορισμό των πραγματικών αναγκών στην Υγεία [βίντεο] Δ. Νίκας στο Healthcare Transformation: Οι επιπτώσεις από την υστέρηση της καινοτομίας στην Ευρώπη [βίντεο]
Δ. Νίκας στο Healthcare Transformation: Οι επιπτώσεις από την υστέρηση της καινοτομίας στην Ευρώπη [βίντεο] ΕΚΑΒ: Ειδική υπηρεσία για διακομιδές ασθενών σε ψυχιατρεία με εισαγγελική εντολή
ΕΚΑΒ: Ειδική υπηρεσία για διακομιδές ασθενών σε ψυχιατρεία με εισαγγελική εντολή Αρχική συμφωνία για την απόκτηση της Innovis Pharma από τη PharmaPath
Αρχική συμφωνία για την απόκτηση της Innovis Pharma από τη PharmaPath Ελ. Τοκατλίδη στο Healthcare Transformation: Σε 20 - 40 μέρες φάρμακα στην Ελλάδα μέσω ΙΦΕΤ [βίντεο]
Ελ. Τοκατλίδη στο Healthcare Transformation: Σε 20 - 40 μέρες φάρμακα στην Ελλάδα μέσω ΙΦΕΤ [βίντεο] Πώς θα γίνουν οι δωρεάν προληπτικές εξετάσεις για την παχυσαρκία - Εκδόθηκε η ΚΥΑ
Πώς θα γίνουν οι δωρεάν προληπτικές εξετάσεις για την παχυσαρκία - Εκδόθηκε η ΚΥΑ Αύξηση ιατρικής αμοιβής κατά 30% ανακοίνωσε ο υπουργός Υγείας στην παρουσίαση του βιβλίου Πατούλη
Αύξηση ιατρικής αμοιβής κατά 30% ανακοίνωσε ο υπουργός Υγείας στην παρουσίαση του βιβλίου Πατούλη